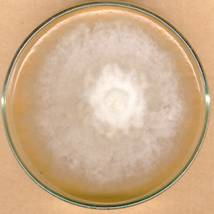

Fungus (mantar) nedir
Bitkilerde hastalık oluşumuna neden olan ipliksi yapıdaki mikro organizmalardır. Bu ipliksi yapılar beyaz, sarı, yeşil, turuncu vb. renklerde olabilmektedir. Aşağıda özel bir besi ortamında geliştirilmiş beyaz renkli fungus kolonisi görülmektedir.
Resim 1. Fungus kolonisi
Havada, toprakta, bitki üstünde çok sayıda fungus ve diğer mikro organizmalar bulunmaktadır. Bunların bir kısmı bitkilerde hastalık oluşumuna neden olmaktadır. Bu bölümde sadece bitkilerde hastalık oluşumuna neden olan funguslar ile ilgili bilgilere yer verilecektir.
Funguslar meyve ağaçlarının nerelerinde hastalık oluşumuna neden olurlar
Funguslar ağaçların yapraklarında, çiçeklerinde, meyvelerinde, sürgün, dal ve gövdelerinde, iletim demetlerinde (ağaçların yaşamı için gerekli olan su ve besin maddelerini taşıyan gözle görülemeyecek kadar ince borucuklar), köklerinde hastalık oluşumuna neden olmaktadır.
Bu bölümde meyve ağaçlarında hastalık oluşturan funguslar oluşturdukları belirti tipine göre gruplandırılarak incelenecektir.
Belirti tipine göre hastalıklar
Leke hastalıkları
Bazı funguslar meyve ağaçlarının yapraklarında, meyvelerinde ve sürgünlerinde leke oluşumuna neden olmaktadır. Yaprak ve meyvelerde oluşan lekeler genellikle yuvarlaktır. Yaprak ve meyvenin gelişim döneminde hastalığın şiddetli olarak görüldüğü yerlerde çok sayıdaki yuvarlak lekeler meydana gelir. Bazen bu lekeler birleşerek daha büyük lekelerin oluşumuna ve yaprağın ya da meyvenin şeklinin bozulmasına neden olmaktadır. Sürgünlerdeki lekeler ise genellikle elips şeklindedir.
Aşağıda bazı meyve ağaçlarında fungusların oluşturduğu leke hastalıkları ile ilgili bilgiler ve resimleri yer almaktadır.
Elma kara lekesi hastalığında yaprakta önce yağ lekeleri oluşur, daha sonra bu lekelerin rengi zeytin yeşiline, en sonunda da kahverengine dönüşür. Meyve lekeleri ise önce yeşilimtırak olup sonra kahverengine dönüşür.

Resim 2. Karalekeli yaprak.

Resim 3. Karalekeli meyve.
Taş çekirdekli meyvelerde yaprak delen hastalığında da yaprakta önce 1 mm çapında yağ lekesi oluşur, daha sonra kenarları kırmızımtırak renkli ortası kahve rengi lekeler meydana gelir, daha sonra lekeli kısım dökülür ve hastalık için tipik delikli bir görünüm olur. Bu hastalığın kayısı meyvelerindeki belirtisi, 1-2 mm çapında, yuvarlak, lekelerin ortaları koyu, etrafı açık kırmızımsı renktedir, zamanla ortası gri, kirli beyaz, çevresi koyu kırmızı, koyu kahverengi veya siyaha dönüşmektedir. Lekelerin orta kısmı kahverengi ve çöküktür.


Resim 4. Yaprak delen hastalığının meyvedeki ve yapraktaki belirtileri.
Zeytinde Halkalı leke hastalığında, ilkbaharda yaprakların üst yüzeylerinde siyahımsı-gri renkte yuvarlak noktalar şeklindeki lekeler meydana gelir. Bu noktaların bulunduğu yerde renk açılır, daha sonra bunun çevresinde normal yaprak renginde bir halka oluşur. Bunu dıştan ikinci bir açık renkli halka çevirir. Sonra tekrar koyu renkli bir halka oluşur. Bu gürünüm nedeniyle hastalığa halkalı leke hastalığı adı verilir.


Resim 5. Zeytinde Halkalı leke hastalığının yapraktaki görüntüsü.
Külleme ve mildiyö hastalıkları
Külleme hastalıkları: Külleme hastalıklarına, konukçu bitkisine göre, farklı funguslar neden olmaktadır. Ancak oluşturdukları belirtilerde biraz farklılıklar olmasına rağmen külleme hastalığının ortak belirtileri şunlardır:
önce yapraklarda yağlımsı bir görünüş ve renk açılması meydana gelir, daha sonra yaprakların alt ya da üst yüzeylerinde unsu görünüşte, beyaz yüzeysel lekeler oluşur. Hasta yaprakların şekli bozulur.
Külleme hastalığının sürgündeki belirtileri konukçu bitkiye göre farklılıklar göstermektedir. örneğin, elma ve şeftali sürgünleri üzerinde beyaz unsu görünüşte bir tabaka oluşurken, bağ sürgünleri üzerinde önce kahvemsi-siyah, kışa doğru kırmızımsı kahverengi lekeler oluşur.
Külleme hastalığının tüm konukçu bitkilerin meyveleri üzerindeki ilk belirtisi aynıdır. Meyvelerin üzerinde beyaz renkli fungal örtü görülmektedir. Ancak daha sonraki aşamalarda, şeftali ve elmada küçük, şekilsiz meyveler oluşurken, bağda salkımlardaki irileşebilen taneler sapı doğrultusunda çatlar.

Resim 6. Salkımda Külleme.

Resim 7. Bağ yaprağında Külleme.

Resim 8. Bağ sürgününde Külleme.
Mildiyö hastalığı: Bağ mildiyösü hastalığında başlangıçta yaprağın üst yüzeyinde sarı renkli tipik yağ lekeleri meydana gelir. Daha sonra yaprağın alt yüzünde beyaz bir fungal örtü oluşur. Bu lekelerin rengi zamanla kahverengileşir, kurur ve dökülür. Sürgünler üzerinde elips şeklinde lekeler meydana gelir. Hastalıklı taneler olgunluk dönemine doğru su kaybederek buruşur meşinleşmiş bir görünüm alırlar.

Resim 9. Yaprağın alt yüzünde Mildiyö lekesi.

Resim 10. Yaprağın üst yüzünde Mildiyö lekesi.

Resim 11. Mildiyö zararına uğramış taneler.
Şekil Bozuklukları
Buna en tipik örnek şeftalide yaprak kıvırcıklığı hastalığıdır. Hastalıklı genç yaprakların rengi önce sarı veya beyazımtıraktır. Daha sonra bu yapraklarda büzülme ve spiral şeklinde bükülme görülür. Bazen hastalıklı yapraklar kırmızımtırak veya şarap tortusu rengine dönüşebilir. Hastalıklı bölümler sert, kırılgan ve normal yapraklardan daha kalındır.

Resim 12. Şeftalide Yaprak kıvırcıklığı.
Yanıklık ve Çürüklükler
Yanıklık: Taş çekirdekli meyve ağaçlarında çiçek monilyası hastalığında çiçekler tüm organları ile birlikte kahverengileşir, kuruyarak zamk akıntısı ile birlikte dal üzerinde asılı kalır. Çiçek sapından enfekte olan sürgünler ise esmerleşir, ince sürgünler tamamen kurur.

Resim 13. Çiçekte Monilya hastalığı.
Çürüklükler: Meyve monilyası hastalığında meyve kabuğunda önce kahverengi lekeler meydana gelir, daha sonra bu lekelerin etraflarında, açık kahverengi bir halka oluşur. Meyvenin çürüyen kısmında sarı-devetüyü renkli içi içe halkalardan oluşmuş çıkıntılar meydana gelir. Sonunda hastalıklı meyve dokusu hızla su kaybederek buruşur ve mumyalaşarak dalda asılı kalır.

Resim 14. Kirazda sağlam ve Monilya zararı görmüş meyveler.
Bağda kurşuni küf hastalığında, tanelerde yuvarlak, pembemsi, kızıla yakın lekeler halinde görülür. Leke büyüdükçe rengi de koyulaşır. Hastalık ilerledikçe salkım ve taneler gri renkte bir küf tabakasıyla kaplanır. Taneler çatlar, çok ileri devrede buruşur ve meşinleşmiş gibi bir hal alır.

Resim 15. Bağda Kurşuni küf.
Turunçgillerde Yeşilküf ve maviküf çürüklüğü hastalıklarında, meyve kabuğunun herhangi bir yerinde yumuşama şeklinde başlar. Sonra lekenin ortasından başlayarak beyaz renkli bir tabaka oluşur. Daha sonra merkezden başlayarak yeşil renkli ya da mavi renkli fungal kitleler oluşur. Meyve büzülür, mumyalaşır.

Resim 16. Turunçgillerde Yeşil küf.
Turunçgil meyvelerinde kahverengi çürüklük hastalığında, enfeksiyon noktasında önce kahverengi-sarı lekelenme olur ve kabuk yumuşar, sonra tüm meyveyi hastalık sarar. Meyve kabuğu biraz incelip kahverengi derimsi bir hal alır.

Resim 17. Turunçgil meyvelerinde kahverengi çürüklük.
Geriye ölüme neden olan hastalıkların hepsinde ortak belirti tipi şöyledir :
*Hasta ağaçların yaprakları sararır ve kurur.
*Sürgün ve dallar uçtan geriye doğru kurumaya başlar
*Sonuçta ağaçlar tamamen kurur.
Geriye ölüm belirtilerine, kök çürüklüğü hastalıkları, iletim demeti hastalıkları ve kanserler neden olmaktadır.
Aşağıda geriye ölüm belirtisine neden olan hastalıklar ve belirtileri yer almaktadır.
Kök Çürüklükleri
Armillaria ve Rosellinia kök çürüklüğü hastalığında ağaçların kök boğazına kadar olan kısmında, kabuk dokusu ile odun dokusu arasında beyaz fungal tabaka meydana gelir.

Resim 18. Armillaria ve Rosellinia kök çürüklüğü.
Turunçgillerde gövde zamklanma hastalığında, gövdede hasta bölgenin kabuğu dıştan sertleşmiş kuru görünüm alır. Bu bölgede kabuk çatlar ve kahverengi zamk akıntısı olur. Hastalık gövdede yatay ve dikey olarak ilerleyerek tüm gövdeyi sarar ve öldürür, odun dokusu kahverengi-sarımsı renk alır. Kök boğazında ve toprak altındaki ana ve saçak köklerde hastalık nedeniyle kahverengi çürümeler oluşur. Hastalanan bu bölgeler sertleşir ve hafif bir zamk akıntısı yapar.

Resim 19. Turunçgillerde Gövde zamklanma hastalığı.
İletim Demeti Hastalıkları
Verticillium solgunluğu hastalığına neden olan fungus, başta zeytin ağacı olmak üzere taş çekirdekli meyve ağaçlarında, antep fıstığı ağaçlarında iletim demeti denilen su borucuklarının tıkanmasına neden olarak kökten bitkinin üst kısımlarına doğru olan su iletiminin azalmasına ya da tamamen engellenmesine neden olur.

Resim 20. Verticillium solgunluğu hastalığı.
Turunçgillerde Uç kurutan hastalığında, uçtaki taze sürgünler öldükçe, hastalık su iletim borularından aşağı doğru ilerleyerek çok yıllık kalın dallara kadar iner. Böylece köke kadar ulaşan hastalık tüm ağacı kurutur. Yeni kurumuş dalların enine kesitindeki turuncu-koyu kahverengi renklenme, hastalığın tipik belirtilerinden biridir.


Resim 21. Turunçgillerde Uç kurutan hastalığı.
Kanserler
Kestane kanseri hastalığı ağacın dal ve gövdesinde belirti oluşturur. Kabuk dokusu önce normal yeşil, kahve rengini kaybeder ve renk kızıl kahve olur, daha sonra hastalıklı kabuk dokusu odun dokusuna kadar çatlar. Kabuktaki iletim demetleri hastalandığı için hastalıklı kısmın üst tarafına besin maddesi ve su iletimi olamaz ve ağaçlar uçtan geriye doğru kurumaya başlar ve sonunda ağaçlar tamamen kurur.


Resim 22. Kestane kanseri hastalığı.
Sebzelerde Belirti Tiplerine Göre Fungal Hastalıklar
Çimlenme ve Fide Döneminde ölümler
Çökerten: Genellikle fideliklerde görülür. Çıkış öncesi ve çıkış sonrası olmak üzere iki ana belirti tipi vardır. Çıkış öncesi çökertende, bitkiler çimlenip toprak yüzüne çıktıkları dönemde fidelikte yer yer boşlukların olması ile kendini gösterir. Bu bölgedeki bitkiler çimlenme esnasında öldükleri için bu bölgelerde çıkış olmamaktadır. Çıkış sonrası Çökerten de ise fidelikte bitkiler toprak yüzeyine çıktıktan sonra kök boğazından devrilip toprak yüzeyine serilirler. Bu tür bitkiler kısa bir süre sonra kurur. Çökerten belirtileri fidelik dışında bazı ürünler de özellikle tohumu direk tarlaya ekilen bitkilerde de görülebilir.


Resim 23. Fideliklerde Çökerten hastalığı.
Kök çürüklüğü: Genelde tarlada bitkilerin gelişme döneminde ortaya çıkar. Bitkileri kök ve kök boğazında koyu renkli hafif çökük lekeler şeklinde ortaya çıkar bu tür bitkiler tam olarak gelişemez. Eğer kök ve kök boğazındaki lekeler kök veya kök boğazını tamamen çevreler ise bu tür bitkiler zamanla kururlar.

Resim 24. Kök çürüklüğü hastalığının kök ve kök boğazındaki belirtileri.
Gelişme döneminde ölümler
Leke ve Yanıklık Hastalıkları
Bitkilerin toprak üstü organlarından olan gövde, yaprak, çiçek ve meyvelerinde görülür. Lekelerin şekli rengi ve iriliği her hastalığa göre değişir. Genelde uygun koşullarda lekelerin altında veya üstünde hastalık etmenin üreme organları meydana gelir.
Leke Hastalıkları
Külleme Hastalıkları: Külleme hastalığı neden olan birçok etmen mevcuttur. Ancak bitkilerde benzer belirtilere neden olurlar. Genel olarak hastalık, bitkilerin alt yapraklarından başlar. Daha sonra taze yapraklara ve sürgünlere geçer. Küllemenin bitkideki görünüşü yaprakların genelde üst yüzünden bazen hem alt hem de üst yüzünden un serpilmiş gibi lekelerin oluşudur. Lekeler zamanla birleşerek bütün yaprağı kaplar. Küllemeli bitkiler büyüyemez, çiçek açmaz, meyveler tatsızlaşır. Hastalık çok ilerlemişse yaprak ve meyve dökümü olur. Hastalık kışı bitkilerin yaprakları üzerinde siyah renkte, yuvarlak üreme organı halinde geçirir. Baharda bu üreme organı gelişerek burada meydana gelen sporları etrafa yayılır ve yeni bitkilerde hastalık oluşur.


Resim 25. Külleme Hastalığının yaprak üst yüzeyindeki belirtileri.
Diğer leke hastalıkları: Külleme hastalıkları grubu dışında sebzelerde mevcut birçok leke hastalıkları
Yaprak küfü: Bitkideki belirtiler yaprakların üst yüzeyinde küçük,vaçık yeşil veya sarımsı bölgeler olarak başlar. Lekelerin altında zeytini kahverengi küf tabakası oluşur. Hastalık ilerledikçe yapraklar kurur ve bitki ölür.

Resim 26. Yaprak küfü hastalığının belirtileri.
Septoria yaprak leke hastalıkları: Genelde hastalık alt yaprakların alt yüzeyinde haşlanmış gibi gözüken küçük ve yuvarlak noktalar şeklinde başlar. Noktalar ilerledikçe kenaralrı koyu kahverengi orta kısmı çökük ve gri bir renk alır. Bazı önemli septoria hastalıkları şunlardır. Septoria lycopersici (Domates), Septoria melongenae( Patlıcan), Septoria cucurbitacearum (Hıyar, Kavun), Septoria apiicola( Domates, marul, maydanoz, soğan, kereviz ve kabak)
Pas hastalıkları: Hastalık genellikle yapraklarda görülür. Ancak bunların dışında tohum kapsülleri üzerinde ve meyvelerde de görülebilir. Başlangıçta açık sarı renkli küçük püstüller şeklinde belirir. Püstül lekelerinin etrafında sarı renkli bir halka bulunur. Zamanla lekelerin rengi koyulaşır ve siyahımsı kahverengine döner. Bazı önemli pas hastalıkları şunlardır. Uromyces phaseoli (Fasulye), Uromyces fabae (Bakla), Uromyces pisi (Bezelye), Puccinia apii (Kereviz)

Resim 27. Pas hastalığının yaprak yüzeyinde oluturduğu lekeler.
Yanıklık Hastalıkları
özellikle yaprak, çiçek ve sürgünlerde sık rastlanan, kısa sürede hızla ilerleyip büyüyen ve lekelerden farklı olarak sınırları belli olmayan belirtilere yanıklık denir.
Mildiyö Hastalıkları: Mildiyö grubu hastalıklar bitkilerin toprak üstü organlarında (yaprak, gövde, sürgün, çiçek ve meyve) yanıklıklara neden olur. Hastalık genellikle genç yapraklarda haşlanmış bir manzara şeklinde belirir. Hastalıklı yaprağın alt yüzeyinde hastalıklı dokuların kenar kısımlarında küf tabakası oluşur. Hastalık meyvelerde de görülebilir. En önemli Mildiyö etmenleri olarak Phytophthora infestans (Patates ve domates mildiyösü), Peronospora tabacina (Tütün mildiyösü), Pseudoperonospora cubensis (Hıyar, kavun), Peronospora destructor (Soğan mildiyösü) sayılabilir.

Resim 28. Mildiyö hastalığının domatesteki zararı.
Antraknoz: Çeşitli sebze, baklagil, endüstri ve süs bitkilerinde yanıklık belirtisine ek olarak leke ve çökük yaralar oluşturan ve bu yaralar üzerinde spor yataklarını oluşturan fungal etmenlerdir. Yapraklarda sarımsı lekeler oluşur. Daha sonra bu lekeler kahverengi veya siyaha dönüşür. Sap ve Meyveler üzerinde de çökük lekeler meydana gelir. En önemli antraknoz hastalıkları arasında Colletotrichum lagenarium (Hıyar antraknozu), Colletotrichum trifolii yonca antraknozu, Glomerella lindemuthianum(fasulye)olarak sayılabilir.


Resim 29. Antraknoz hastalığının gövde ve kapsüldeki zararı.
Çürüklükler
Çürüklükler taze sebzelerde çoğu zaman olgunluğa yakın ya da olgunluk zamanında bahçede başlayıp depoda devam eden doku bozulmalarıdır. Çürüklükler renklerine göre, çürüttüğü bitki organlarına göre ve çürüklüğün durumuna göre (Yumuşak ve Kuru) isimlendirilirler. Sebzelerde yumru çürüklükleri önemlidir. Birçok yumrusu yenen sebze bu çürüklük etmenlerinin saldırısı sonucunda çürümektedir
Kuru çürüklük: patates yumrularında görülür Fusarium spp türleri neden olur. Yumruda koyu renkli, çökük lekeler şeklinde kendini gösterir. Çürüklük ilerledikçe yumru içinde boşluklar oluşur. Ve fungusun gelişme organları ipliksi şeklinde görülür.


Resim 30. Patates yumrusunda kuru çürüklük.
Beyaz çürüklük: Hastalığa yakalanan dokularda (gövde, kökboğazı, dal ve meyve) ilk önce bir yumuşama görülür. Yumuşayan dokular cıvıklaşırken üzerleri küf ile kaplanır. İleri dönemde bu küfleri arasında dayanıklı yapılar meydana gelir.
Beyaz çürüklük etmenleri sebzelerin hemen hepsini hastalandırabilmektedirler.

Resim 31. Beyaz çürüklük hastalığı.
Solgunluk
Solgunluk bitkide turgor basıncının düşmesi ve herhangi bir nedenle hücrelerde ve dokularda suyun yeteri kadar gidememesi sonucunda bitkinin solması, pörsümesidir. Bu tür bitkilerde önce alttan itibaren sararma ve solma şeklinde hastalık ortaya çıkar,. Daha ileri dönemde bitki tamamen sararır ve solar. Solgunluk bazen bitkide asimetrik olarak da ortaya çıkar. Yani bitkinin bir tarafı solarken diğer yanı yeşil kalmaktadır. Ancak yine ilerleyen dönemde solma tüm bitkiyi kapayarak bitkinin ölmesine neden olur.
Hastalıklı bitkilerin toprağa yakın kısmından gövdeden kesit alındığında kahverengi bir halka görülür. Bu belirti bize iletim denmelerinin tıkandığını gösterir.

Resim 32. Solgunluk hastalığı.
Funguslar Nasıl Taşınır ?
Hastalıklı bitki dokusunda yaşayan funguslar ve bunların üreme birimleri hava yada toprak yoluyla sağlıklı bitki dokusuna taşınmakta ve orada yeni hastalık oluşumuna neden olmaktadır. Hastalığın sorun olduğu yerlerden alınan fidanların temiz alanlara dikilmesi de fungusun taşınması ve bulaşmasındaki diğer bir yoldur.
Hava yolu ile: Genellikle bitkinin toprak üstü kısımlarında hastalık oluşumuna neden olan funguslar ve üreme birimleri hava yolu ile yayılırlar. Hava yoluyla yayılma rüzgarla, kuşlarla, böceklerle, yağmur damlaları ile olmaktadır. Böylece meyve ağacının yaprak, meyve ve sürgünlerine ulaşan funguslar buralarda leke hastalıklarının, külleme ve mildiyö hastalıklarının, çürüklük ve yanıklık hastalıklarının oluşmasına neden olurlar. Turunçgillerde uç kurutan ve kestane kanseri hastalıklarına neden fungusların yayılması da hava yolu ile olmaktadır ancak bu hastalıkların sağlıklı ağaçlara bulaşmasında budama aletlerinin yeri çok önemlidir.
Toprak yolu ile: Toprak kökenli hastalıklardan Armillaria ve Rosellinia kök çürüklüğü hastalıkları, Verticillium solgunluğu hastalığı, Turunçgillerde zamklanma ve kahverengi çürüklük hastalığına neden olan funguslar toprak kökenlidir yani toprakta yaşamlarını sürdürmektedirler. Bu nedenle fungusun bahçe içindeki yayılması da toprak yolu ile, sulama suyu ve toprak işleme aletleri ile olmakta ve bahçenin temiz taraflarına taşınarak oralarda da hastalık oluşumuna neden olmaktadırlar. Verticillium solgunluğuna neden olan hastalık etmeni fungusun sağlıklı ağaçlara bulaşmasında budama aletlerinin rolü çok önemlidir.
Toprakta yaşayan funguslar hastalıklı fidanların temiz bahçelere dikilmesi ile yada hastalık etmeni fungus ile bulaşık yerlerden alınan toprağın temiz bahçelerde kullanılması da fungusun yayılma ve bulaşmasında önemli bir faktördür. Bu funguslar toprak yolu ile köke ulaşarak hastalık oluşumuna neden olmaktadır. Armillaria ve Rosellinia kök çürüklüğü hastalığında fungus kök ve kök boğazında çürüklüğe, Verticillium solgunluğu hastalığında fungus iletim demetlerini tıkayarak ağaçlarda solgunluğa neden olmaktadır. Turunçgil ağaçlarında zamklanma hastalığına neden olan fungus kök, kökboğazı ve kalın dallarda belirti oluşumuna neden olurken, aynı fungus ağaç üstündeki meyvelerde (yerden 1,5 m yüksekliğe kadar olan) ise kahverengi çürüklük hastalığına neden olmaktadır. Meyve enfeksiyonu sonbaharda yağan yağmurlar sırasında yerden sıçrayan damlalarla olmaktadır.
Tohum, Yumru, Soğan vb. Üretim materyali ile taşınma: Birçok fungus üretim materyali olarak kullanılan tohum, yumru, soğan gibi bitki organlarının üzerinde ya da içinde bulunur. Bazı funguslar için tek yol tohumla taşınma da değildir. örneğin patates mildiyösü yumru ile taşınabildiği gibi sporları hava yolu ile de taşınabilmektedir. Son yıllarda verimli, kaliteli, hastalıklara dayanıklı tohum ve diğer üretim materyaline çok büyük önem verilmektedir.
Facebook'ta Yayınla>